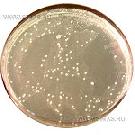
Lysine Agar
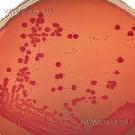
MacConkey Agar (without salt)
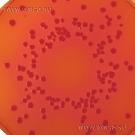
MacConkey Agar (with salt)
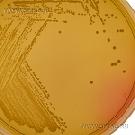
Mannitol Salt Agar
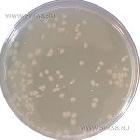
Microbial Content Test Agar (M.C.T.A.)
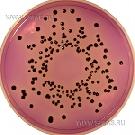
MLCB Agar (Mannitol Lysine Crystal violet Brilliant green)
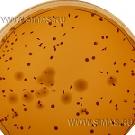
M.R.S. Agar
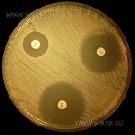
Mueller-Hinton Agar

Подписаться на рассылку
Компания СИМАС
Москва, Варшавское шоссе д.125 стр.1
+7 (495) 980 - 29 - 37, +7 (916) 942 - 65 - 95
info@simas.ru
|
Полный перечень сред Lab M
1 | 2 | 3 | 4 | 5 | 6 | 7
Lysine Agar
Производитель: Lab M
Описание: Агар лизиновый для подсчета "диких" дрожжей.
Этап: Исследование |
|
|
|
Lysine Iron Agar
 Производитель: Lab M
Описание: Агар лизиновый с железом для дифференциации патогенных энтеробактерий.
Этап: Исследование |
|
|
|
M 17 Agar
 Производитель: Lab M
Описание: Агар М17 для подсчета молочнокислых стрептококков.
Этап: Исследование |
|
|
|
MacConkey Agar No.2
 Производитель: Lab M
Описание: Агар Мак-Конки для выявления энтерококков в присутствии колиформных бактерий и Lac(-) бактерий в воде, сточных водах, пищевых продуктах. (см. также Harlequin™ SMAC-BCIG - агар с сорбитолом и хромогенной добавкой D-глюуронидом)
Этап: Исследование |
|
|
|
MacConkey Agar № 3
 Производитель: Lab M
Описание: Агар Мак-Конки № 3. для выделения энтеробактерий из воды и сточных вод.
Этап: Исследование |
|
|
|
MacConkey Agar (without salt)
Производитель: Lab M
Описание: Агар Мак-Конки для дифференциации энтеробактерий.
Этап: Исследование |
|
|
|
MacConkey Agar (with salt)
Производитель: Lab M
Описание: Агар Мак-Конки селективный для выделения бактерий, толерантных к желчи.
Этап: Исследование |
|
|
|
MacConkey Broth Purple
|
Malt Extraсt Agar
 Производитель: Lab M
Описание: Агар с солодовым экстрактом с кислой рН для выделения большинства плесеней и дрожжей.
Этап: Исследование |
|
|
|
Malt Extract Broth
 Производитель: Lab M
Описание: Бульон на солодовом экстракте для выделения плесеней и дрожжей при контроле стерильности.
Этап: Исследование |
|
|
|
Mannitol Salt Agar
Производитель: Lab M
Описание: Агар солевой с маннитом для выделения штаммов стафилококка, толерантных к хлористому натрию.
Этап: Исследование |
|
|
|
Maximum Recovery Diluent
 Производитель: Lab M
Описание: Бульон, осмотически сбалансированный для разведений.
Этап: Исследование |
|
|
|
Membrane Lauryl Sulphate Broth
 Производитель: Lab M
Описание: Бульон с лаурил-сульфатом для исследования воды методом мембранных фильтров.
Этап: Исследование |
|
|
|
Microbial Content Test Agar (M.C.T.A.)
Производитель: Lab M
Описание: Агар для определения микробной обсемененности рабочих поверхностей после санитарной обработки.
Этап: Исследование |
|
|
|
Milk Agar
 Производитель: Lab M
Описание: Агар молочный для подсчета микроорганизмов в молочных продуктах.
Этап: Исследование |
|
|
|
Milk Plate Count Agar
 Производитель: Lab M
Описание: Агар на обезжиренном молоке для подсчета живых бактерий в молоке и молочных продуктах.
Этап: Исследование |
|
|
|
Minerals Modified Glutamate Medium
 Производитель: Lab M
Описание: Cреда жидкая с глутаматом модифицированная для подсчета колиформных бактерий в воде методом НВЧ.
Этап: Исследование |
|
|
|
MLCB Agar (Mannitol Lysine Crystal violet Brilliant green)
Производитель: Lab M
Описание: Агар селективный с маннитом, лизином, кристалл-виолетом и бриллиантовым зеленым для выделения сальмонелл (кроме S.typhi и S. paratyphi А).
Этап: Исследование |
|
|
|
Modified Lauryl Sulphate Tryptose Broth with MUG & Tryptophan (ISO) (MLSTB-MT)
 Производитель: Lab M
Описание: Бульон триптозный с лаурилсульфатом для предварительного подсчета E.coli в молоке и молочных продуктах по стандарту ISO 11866-1:2005.
Этап: Исследование |
|
|
|
Modified Tryptone Soy Broth - MTSB (O157 Broth)
 Производитель: Lab M
Описание: Бульон триптонно-соевый модифицированный (MTSB) для селективного обогащения энтеротоксигенных штамммов E.coli.
Этап: Исследование |
|
|
|
Modified Preston Campylobacter Medium
 Производитель: Lab M
Описание: Агар Престона модифицированный для выделения Campylobacter spp. на основе кровяного агара № 2 -Blood Agar Base № 2.
Этап: Исследование |
|
|
|
Modified Preston Campylobacter Medium
 Производитель: Lab M
Описание: Бульон Престона модифицированный для выделения Campylobacter spp. на основе питательного бульона № 2 (ВР) - Nutrient Broth № 2.
Этап: Исследование |
|
|
|
M.R.S. Agar
Производитель: KOEHLER INSTRUMENT
Описание: Агар MRS для культивирования и подсчета лактобактерий.
Этап: Исследование |
|
|
|
M.R.S. Broth
 Производитель: Lab M
Описание: Бульон MRS для культивирования и подсчета лактобактерий.
Этап: Исследование |
|
|
|
MSRV Medium (Semi Solid Rappaport Medium)
 Производитель: Lab M
Описание: Среда модифицированная полужидкая Раппапорта-Вассилиадиса для быстрого обнаружения подвижных типов сальмонелл.
Этап: Исследование |
|
|
|
Mueller-Hinton Agar
Производитель: Lab M
Описание: Агар Мюллера-Хинтона для определения чувствительности бактерий к антибиотикам (по стандарту NCCLS - Институт клинических и лабораторных стандартов).
Этап: Исследование |
|
|
|
Mueller-Hinton Broth
 Производитель: Lab M
Описание: Бульон Мюллера-Хинтона для определения чувствительности бактерий к антибиотикам методом серийных разведений в пробирках и определением значений МИК (по стандарту NCCLS).
Этап: Исследование |
|
|
|
Mueller-Kauffmann Tetrathionate Broth
 Производитель: Lab M
Описание: Бульон тетратионатный Мюллера-Кауфмана для селективного обогащения сальмонелл.
Этап: Исследование |
|
|
|
Mueller-Kauffmann Tetrathionate Novobiocin Broth (MKTTn)
 Производитель: Lab M
Описание: Бульон тетратионатный Мюллера-Кауфмана c новобиоцином для селективного обогащения сальмонелл по стандарту BS EN ISO 6579:2002.
Этап: Исследование |
|
|
|
New York Medium
 Производитель: Lab M
Описание: Агар селективный Нью-Йорк для выделения Neisseria gonorrhoeae и Neisseria meningitidis (на основе GC-агара).
Этап: Исследование |
|
|
|
1 | 2 | 3 | 4 | 5 | 6 | 7
|